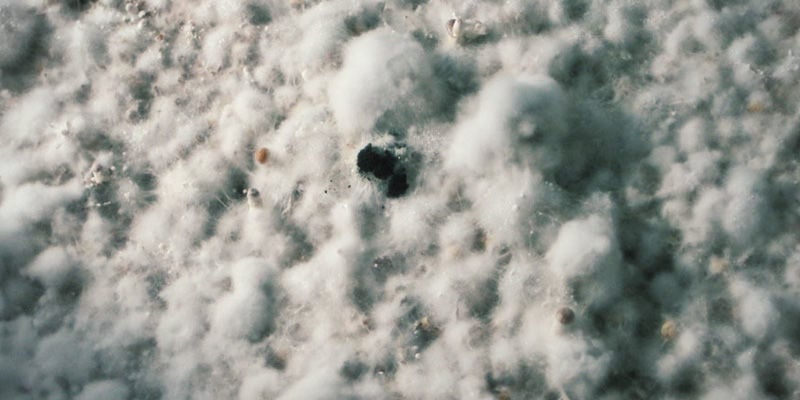

Por favor, inicie sessão para aceder à sua lista de desejos

Escolha sua ferramenta de IA favorita para obter um resumo rápido.
Existe uma grande variedade de contaminações à espreita. A maioria pode ser agrupada em três categorias principais: bactérias, bolores (fungos) e pragas. Vamos analisar mais de perto os tipos mais comuns.
Cultivar cogumelos em casa pode não ser a tarefa mais simples. Não é ciência espacial, mas requer atenção, cuidado e, sobretudo, um ambiente muito limpo, já que é fundamental manter condições estéreis em todos os momentos. Todas as fases da cultura de cogumelos mágicos são sensíveis à contaminação: desde os esporos ao micélio e até os cogumelos em si.
Esterilizar o substrato e filtrar o ar ajuda a manter um ambiente propício ao desenvolvimento do micélio, ao mesmo tempo que evita ameaças como bactérias, bolores ou pragas. No entanto, estas medidas não garantem proteção total. Os processos, apesar de importantes, não são infalíveis e o ambiente estéril dura apenas por um tempo limitado.
De uma forma geral, considera-se contaminação tudo aquilo que não se deseja no substrato ou micélio, principalmente impurezas presentes no ar, solo ou água, que podem comprometer a cultura dos cogumelos a longo prazo. A contaminação por esporos pode ser fatal para toda a cultura, enquanto a contaminação durante a fase de frutificação pode exigir a remoção das cabeças dos cogumelos.
As contaminações propagam-se muito rapidamente; por isso, o melhor é descartar e isolar imediatamente as culturas afetadas das restantes. Por outro lado, a identificação das contaminações é relativamente simples, já que o micélio saudável apresenta uma cor branca uniforme.
Se observar outras cores, é sinal provável de contaminação. No entanto, tenha em atenção dois casos excecionais: o azul, que indica que o micélio sofreu danos físicos (ficou "pisado"), e o amarelo, que revela envelhecimento do micélio e o desenvolvimento de novas defesas contra bactérias.
Os contaminantes proliferam facilmente no substrato esterilizado utilizado para o cultivo de cogumelos, pois neste ambiente não têm concorrência, ao contrário do que acontece na natureza. No habitat natural, a interação entre diversas bactérias, fungos e outros organismos cria um equilíbrio ecológico que permite aos cogumelos desenvolverem-se livremente, sem terem de disputar o domínio do substrato com outros contaminantes.
Como podes ver, existem inúmeros tipos de contaminação que podem afetar este processo. De um modo geral, estes contaminantes dividem-se em três categorias principais: bactérias, bolores (fungos) e pragas.
As bactérias são microrganismos unicelulares que se reproduzem rapidamente e podem ser eliminadas através da pasteurização e esterilização do substrato. Os bolores são fungos que se desenvolvem em filamentos chamados hifas e podem ser controlados com sal, bicarbonato de sódio, álcool, canela, entre outros.
Por fim, existem as pragas: pequenos insetos que atacam as culturas e transmitem doenças que as prejudicam. Estas pragas podem ser combatidas garantindo uma higiene rigorosa e mantendo o espaço de cultivo devidamente isolado.

Encontrar uma cultura de cogumelos contaminada pode ser desanimador. No entanto, é fundamental saber identificar os primeiros sinais e agir em conformidade. Só porque uma cultura ou caixa de frutificação foi afetada, não significa que todo o seu cultivo esteja em risco.
A descoloração é um dos sinais mais evidentes de contaminação. Muitas espécies de bolores invasores apresentam cores vivas e distintas. Se reparar em manchas verdes, azuis, cinzentas ou pretas dentro da sua caixa de frutificação, a cultura provavelmente está contaminada. Tenha em atenção que pequenas manchas azuladas no micélio podem ser apenas hematomas – especialmente onde o centeio pressiona o micélio contra a caixa de cultivo. Estas marcas azuis são normais nestas zonas.
Não são só outros fungos que procuram instalar-se no seu substrato – as bactérias também podem aparecer. A presença de bactérias revela-se muitas vezes pela formação de uma película viscosa. Áreas húmidas e pegajosas nos grãos ou no micélio indicam excesso de humidade e possível contaminação bacteriana. Pode ainda notar manchas acastanhadas ou amareladas, ou texturas crocantes e de aspecto gelatinoso.
Uma cultura de cogumelos saudável desenvolve-se de forma relativamente homogénea no grão ou noutros substratos. As hifas podem espalhar-se em diversas direcções, mas acabam por se juntar e consolidar o meio de crescimento. Se notar formação de "sectores" – zonas onde se formam fronteiras e as hifas não se misturam – pode estar perante contaminação por outra espécie de fungo.
Infelizmente, nem todos os fungos invasores são fáceis de identificar. Existem variedades cuja cor e aparência se camuflam facilmente no micélio cultivado. Contudo, uma observação atenta ajuda a distingui-los. Os esporóforos são um desses casos. Procure estas estruturas com um microscópio. São semelhantes a finos pelos, terminando numa pequena bolha na extremidade.
Uma textura poeirenta também pode ser sinal de contaminação. Depósitos com aspecto de pó na superfície do micélio indicam uma invasão, normalmente só visíveis usando uma lupa.
Detetou sinais de contaminação? E agora?
As caixas de frutificação contaminadas são, na maioria dos casos, uma causa perdida. Abri-las para remover tecido infetado só aumenta o risco para outras culturas e para o seu espaço de cultivo. Em algumas situações, contudo, é possível salvar as culturas de cogumelos mesmo após contaminação. Continue a ler para conhecer os tipos mais comuns de contaminação e possíveis soluções.
Agora que já abordámos os vários tipos de contaminação que podem afetar as suas culturas de cogumelos e explicámos como os pode identificar, vamos apresentar alguns dos exemplos mais frequentes.

Uma situação frequente em frascos de spawn de grão é a presença de bacilos, que por vezes sobrevivem ao processo de esterilização sob a forma de endósporos, resistentes ao calor. Quando o substrato é contaminado por bacilos, forma-se uma camada viscosa de cor cinzenta baça, com um odor desagradável e forte, tornando os grãos excessivamente húmidos, o que justifica o nome atribuído a esta contaminação.
Para eliminar os endósporos do grão, recomenda-se deixá-lo de molho à temperatura ambiente durante cerca de 24 horas. Este procedimento permite que os endósporos germinem e, consequentemente, possam ser eliminados na esterilização.

Se reparar em manchas que vão do amarelo ao castanho nas extremidades ou perto do topo dos chapéus dos cogumelos, é provável que a sua cultura tenha sido afetada por uma infeção bacteriana conhecida como blotch bacteriano. Esta bactéria propaga-se através de partículas de solo transportadas pelo ar e tem maior probabilidade de surgir quando os cogumelos permanecem húmidos entre 4 a 6 horas, ou mais, após a rega. O controlo desta doença passa por reduzir a humidade e aplicar uma solução de cloro com uma concentração de 150ppm.

Se notar um micélio com aspeto de algodão a cobrir a sua camada de cultivo e a envolver os cogumelos com um micélio suave que acaba por apodrecê-los, é provável que a sua cultura esteja contaminada com bolor de teia. Este bolor tem uma tonalidade ligeiramente mais escura do que o micélio habitual, sendo uma diferença subtil que pode passar despercebida a quem está a começar.
Outro sinal claro é a rapidez com que se propaga, já que o bolor de teia consegue ocupar toda a superfície do substrato em apenas um ou dois dias, normalmente a partir de uma pequena mancha. Ambientes de elevada humidade promovem o crescimento deste contaminante; por isso, reduzir a humidade ou aumentar a circulação de ar pode ser uma boa forma de travar o problema.

O bolor verde é provocado pelo Trichoderma harzianum e caracteriza-se por um micélio branco e agressivo, capaz de cobrir todo o substrato e os cogumelos, causando podridão mole e a formação de esporos de cor verde esmeralda. Actualmente, esta é a doença mais comum na indústria de Agaricus nos Estados Unidos.
Maus hábitos de higiene, presença de moscas, falta de oxigénio e outros factores aumentam a incidência do bolor verde, tornando fundamental manter uma limpeza rigorosa e aplicar desinfetantes em todas as áreas da produção.

Também conhecido como Neurospora, este fungo desenvolve-se rapidamente e é frequentemente encontrado em agar e em grãos. Sendo um contaminante extremamente comum no meio natural, consegue crescer através de tampões de algodão e discos filtrantes, tornando-se bastante difícil de eliminar. Caso a cultura seja contaminada, deve ser descartada de imediato e o laboratório limpo cuidadosamente.
Estes fungos são extremamente comuns em culturas de ágar e grão, já que conseguem desenvolver-se facilmente em quase todo o material orgânico. Conhecidos como Aspergillus, preferem ambientes com um pH quase neutro a ligeiramente básico e apresentam diferentes tonalidades, do preto ao amarelo. Algumas variedades são tóxicas e podem produzir aflatoxinas perigosas, pelo que devem ser manuseadas com especial precaução.

Esta doença é causada por fungos do género Verticillium, que libertam esporos pegajosos. Os sintomas variam consoante o estágio de desenvolvimento dos cogumelos. Infecções precoces resultam em cabeças deformadas, enquanto infecções mais tardias fazem com que os cogumelos cresçam tortos, com o chapéu inclinado.
Devido ao facto de os esporos serem pegajosos, espalham-se facilmente através do pó, por isso recomenda-se precaução ao movimentar solo perto de zonas de cultivo de cogumelos. Para além disso, é fundamental evitar a entrada de moscas nas áreas de produção e colocar sal sobre papel absorvente para conter a disseminação da doença.

Pequenos insectos voadores que são atraídos pela plantação de cogumelos. Alimentam-se do micélio e escavam túneis dentro dos cogumelos. Os tecidos danificados por estes mosquitos são frequentemente invadidos por bactérias, o que pode provocar podridão mole.
Os adultos medem cerca de 0,3 cm, têm corpo acinzentado a preto e asas translúcidas, sem padrão definido e poucas veias visíveis. Manter uma higiene e limpeza rigorosas é a melhor forma de controlar este tipo de contaminantes.

Os ácaros são pequenos artrópodes frequentemente encontrados em palha e estrume. A maioria das espécies é, na verdade, benéfica para o cultivo de cogumelos, pois alimentam-se de nemátodes e outros ácaros, ajudando ainda na decomposição e mistura do substrato orgânico.
No entanto, existem algumas espécies que podem ser prejudiciais. Tal como os mosquitos-dos-fungos, alimentam-se do micélio dos cogumelos, podendo provocar descoloração à superfície. Para evitar estes contaminantes, é indispensável manter uma higiene rigorosa e práticas de limpeza adequadas.
Estes são os casos de contaminação mais comuns no cultivo de cogumelos. Se há uma lição a retirar, é que um ambiente limpo e um manuseamento cuidadoso são fundamentais para evitar problemas.
Produtos relacionados
Também lhe pode interessar
6 min
2 Maio 2025
Como preparar-se para uma experiência psicadélica em segurança
As experiências psicadélicas tornam-se mais enriquecedoras com planeamento atento e informado. Não é preciso exagerar, mas alguma preparação pode transformar a viagem numa experiência verdadeir ...
6 min
14 Abril 2025
Qual é a diferença entre trufas mágicas e cogumelos mágicos?
Os trufas mágicas e os cogumelos mágicos provêm ambos de espécies de fungos que contêm psilocibina. No entanto, existem diferenças importantes entre eles no que diz respeito à potência, ao pro ...
4 min
24 Novembro 2017
Como identificar diferentes tipos de cogumelos mágicos
Precisa de ajuda para identificar os seus cogumelos mágicos favoritos? Neste artigo, vamos conhecer as variedades mais comuns de cogumelos alucinogénios que pode encontrar. ...
5 min
23 Setembro 2014
Como criar uma plantação de cogumelos mágicos ao ar livre
Os cogumelos são normalmente cultivados em ambientes fechados, mas não tem de ser sempre assim. Com algum micélio, pode facilmente produzir uma reserva anual do sacramento no seu próprio jardim. ...
Categorias
Categorias
Descubra
Informações
Ferramentas
O nosso site não funcionará corretamente sem estes cookies ativados. Por isso, os cookies funcionais não podem ser desativados.